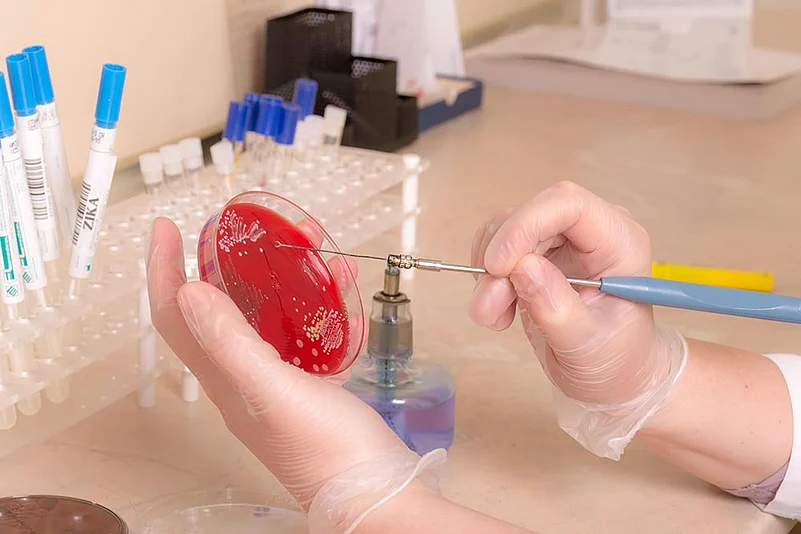

Sushil Kumar, the only Indian to win two Olympic medals in wrestling, will not be in Rio for his fourth successive Games, after losing a court battle seeking a trial to claim a spot. Sushil, now 33, will have to be motivated, fighting fit and lucky in 2020 to have a go at that elusive Olympic gold in Tokyo.
Even if Sushil were to bid farewell before that, it won’t diminish his contribution: He clinched a bronze in 2008 in Beijing and silver at the 2012 London Olympics—both in the 66kg category—after a forgettable 2004 Athens Games.
Sushil, lately hobbled by injuries, lost a bid for an entry ticket to the Rio games after the Wrestling Federation of India (WFI) decided to pick Narsingh Yadav in the 74 kg category.
Sushil challenged the WFI decision, but the Delhi High Court rejected his prayer for a ‘fair trial’. Satpal, his father-in-law, guru and former Asian Games gold-winning wrestler, said that they were considring appealing the high court decision in the Supreme Court. Sushil was forced to compete in the 74kg category after the 66kg category was scrapped after the 2012 Olympics. Narsingh, 26, has been a regular in the 74kg class.
Nonetheless, Sushil’s achievements secure his place among the pantheon of Indian wrestlers. Wrestling is a totally physical sport, and winning an international medal or qualifying for the Olympics takes gruelling work. “I’ve been wrestling since Class VII, or when I was 13 or 14. When Leander won the Olympic bronze in Atlanta 1996, I didn’t grasp its significance; when Karnam Malleswari won the weightlifting bronze in Melbourne 2000, I realised it a bit,” Sushil tells Outlook. “And when I competed in my first Olympics in 2004 and watched Rajyavardhan Singh Rathore win the shooting silver, I realised the grandeur of it all. There is no atmosphere like the Olympics, not even at the World Championships,” admits the diminutive wrestler.
“It has been my dream, and that of Guruji, to win an Olympic gold. He provided me with an international atmosphere at the Chhatrasal Stadium,” he says, referring to the Old Delhi venue where he trains and lives.
Talking about sacrifices needed to excel at the highest level, Sushil says: “If you want to win an Olympic gold, you have to become a sanyasi and train likewise, and not as per your own requirement. Besides you, your family-members too have to make sacrifices.” Sushil claims that while preparing for Rio—before Narsingh was confirmed—he didn’t visit his home for about a year, despite living barely 100 metres away in a small hut-like air-conditioned room in the Chhatrasal Stadium. He only meets his two-year-old twins, sons Suvarn and Suveer, in the evenings and wife Savi off and on.
On failing to win gold in 2008, Sushil was “gutted”. Then, in 2012, he had an upset tummy a day before the bouts (“I was running to the toilet between bouts”, he says). A weak and dehydrated Sushil lost the 66kg final to Japan’s Tatsuhiro Yonemitsu.
“If I had won gold in 2012, I would have quit wrestling. But when I lost the final, I decided to try once more, in 2016, for the gold,” Sushil says. One feels for him to see his fondest dream quashed for now.

Medal Munch
Michael Phelps
‘Flying Fish’, with 22 medals, is the most prolific Olympian. Phelps won six golds and two bronzes in Athens, with two world records. In Beijing, he won golds while making world records in all events but 100 m butterfly. And in 2012, he clinched four golds and two silvers in London. Olympic legend Mark Spitz called him the “greatest Olympian and athlete of all time”.

Dopily Put
Irina Korzhanenko
Russian shot-putter Irina Korzhanenko tested positive for stanozolol at the 2004 Olympics and was stripped of her medal. She claimed innocence and refused to return it to the IOC. She had also been banned for doping in 1999 and was suspended for two years.

Racquet India
Will Paes Play 7th straight Olympics?
Indian fans are hoping that the selection saga of the Indian tennis team for the 2012 London Olympics is not repeated. Rohan Bopanna on June 6 officially figured among the top 10 players on the ATP doubles ranking list, booking a direct berth for Rio, triggering selection talks. The top question: Will Bopanna, who can choose his doubles partner, pick old war-horse Leander Paes (ranked 46), who aims to play his seventh straight Olympics? Of course, the All India Tennis Association will have the final say in picking the team. But Paes (42) is sure that Bopanna and him are the best Indian pair. “My career speaks for itself and Rohan has also been doing well in the last 18 months.... Me and Rohan are the best team,” says Paes. The International Tennis Federation is to e-mail a list of eligible India players to the AITA on June 9; the selection committee is to meet on June 11 to finalise the teams. Sania Mirza is joint world No.1 with Martina Hingis, and is a certainty for Rio. Bopanna looks set to partner Sania.
Sting Scare
Zika Concern Grows
The concern over the mosquito-borne Zika virus is buzzing in the Indian sports ministry, too. In early June, the Steering Group (Core Members) of the Mission Olympic Cell (MOC) noted: “It’s necessary that a team of eminent doctors accompany the Indian contingent. A group of two to three doctors needs to be finalised by IOA. The group of doctors should bring out a compilation of dos and don’ts....”
Elsewhere, leading Aussie golfer Jason Day and members of the US basketball team are undecided about going to Rio, after US cyclist Tejay Van Garderen withdrew over concerns that his pregnant wife could be affected.
With less than two months to go for the Rio Olympics, it’s not an ideal time to call for its postponement, as some, including 150 health experts, have done. Rio officials have advised athletes not to bring their families and to sleep in protective nets. The WHO Emergency Committee will meet to evaluate the risks involved for athletes. But the final decision on holding the Olympics will rest with the IOC. Brazil’s sports minister Leonardo Picciani says the number of Zika virus cases is going down fast and by August there would be none. “We hosted 43 test events in Rio with 7,000 athletes and we have not had any case of Zika or dengue,” Picciani told BBC.

Beach volleyball, one of Rio’s attractions
206 The number of countries, including hosts Brazil, that will be participating at the Rio de Janeiro Games, to be held from August 5-21. Athletes will compete in 306 events of 42 sports. Events will be held at 37 venues. The mascot of the Rio Olympics is named after one of Brazil’s most prominent 20th century cultural icons, Vinicius des Moraes.






















